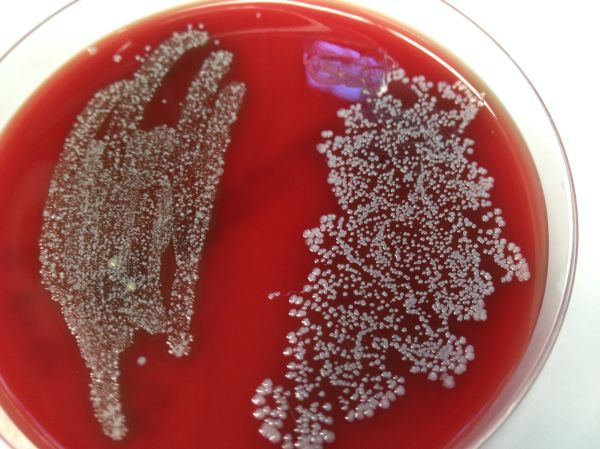
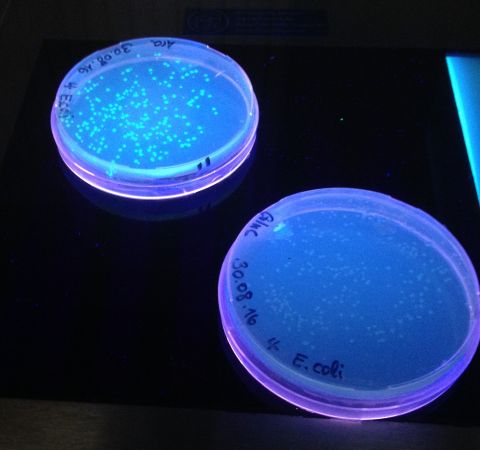

Summerschool im LoLa 29.08. – 02.09.2016
Freie Ferienzeit für einen Laborkurs kürzen? … Warum nicht!
Auch diesen Sommer hatten interessierte SchülerInnen die Möglichkeit, Labor- bzw. Uni-Luft zu schnuppern. Das Lübecker offene Labor (LoLa) bot Laborexperimente und Seminare zum Thema Mikroben – Infektion – Entzündungen an.
Ich bewarb mich im Juli 2016 auf einen der 12 Plätze und freute mich über die Zusage.
Auf dem Programm standen hauptsächlich praktische Laborarbeiten mit Bakterien. Wir züchteten, isolierten, färbten und identifizierten bakterielle Keime, die uns alltäglich umgeben. Außerdem hörten wir in Seminaren spannende Vorträge von renommierten Forscherinnen und Forschern der Uni, die uns alle erdenklichen Fragen beantworten konnten.
Bakterienkolonien wachsen auf einer roten Blut-Agarplatte: links Abstrich aus der Mundhöhle, rechts Abstrich hinter dem Ohr
Uns wurde erklärt, wie unser Immunsystem mit eingedrungenen Bakterien umgeht, wie Entzündungen entstehen, warum immer mehr Antibiotika-Resistenzen auftreten und vieles mehr.
Eine empfehlenswerte Woche für alle Biologie-Interessierten aus der Oberstufe!
Jamine Bernet (Q1d)
Fotos: © Jamine Bernet, Ulrike von Seck